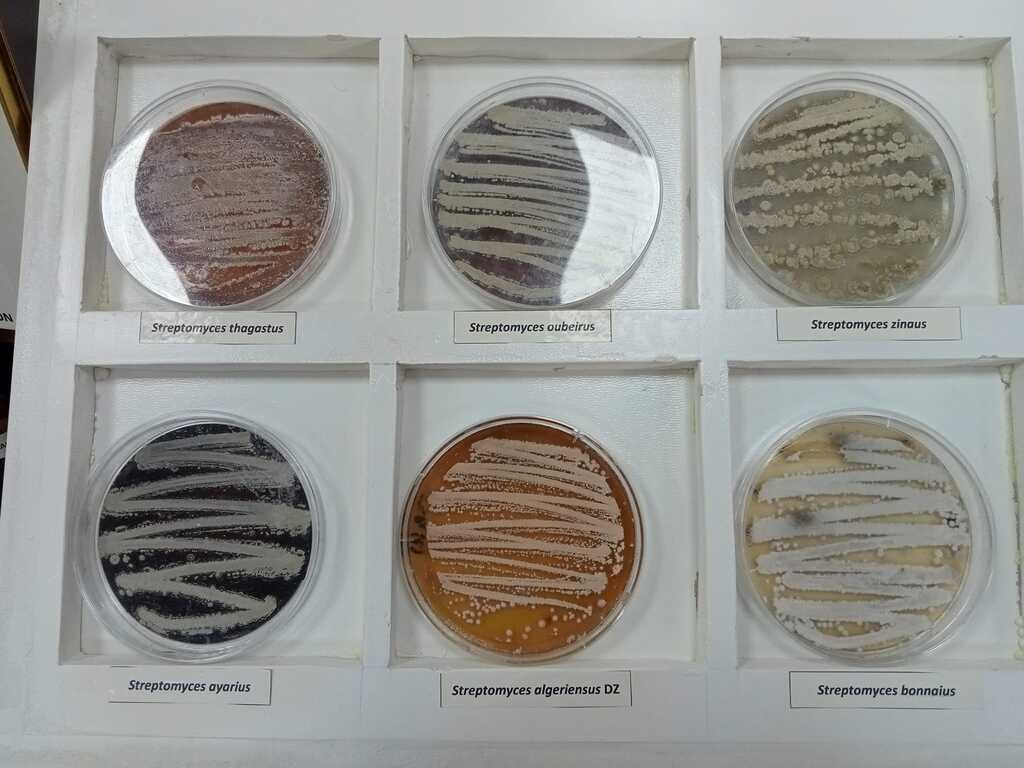

تغطية خلية الإعلام و الإتصال AREN
تغطية خلية الإعلام و الإتصال لمشاركة طلبة وأساتذة الكلية في الاستعراض الذي أشرف عليه السيد وزير التعليم AREN العالي و البحث العلمي.












|
تم وضع هذا الموقع في وضع القراءة فقط لأغراض الأرشفة
الرجاء استخدام الموقع الجديد على: htts://univ-soukahras.dz |
||
|
جــــامـعــة محــمــد الشــريف مسـاعــــدية - ســـوق أهــراس ⵜⴰⵙⴷⴰⵡⵉⵜ ⵎⵓⵃⴰⵎⵎⴰⴷ ⴰⵎⴰⵖⵓⴷ ⵎⵙⴰⵄⴷⵢⴰ ⵙⵓⴽⴰⵀⵔⴰⵙ |
Mohamed Cherif Messaadia University - Souk Ahras Université Mohamed-Chérif Messaadia - Souk Ahras |
تغطية خلية الإعلام و الإتصال لمشاركة طلبة وأساتذة الكلية في الاستعراض الذي أشرف عليه السيد وزير التعليم AREN العالي و البحث العلمي.